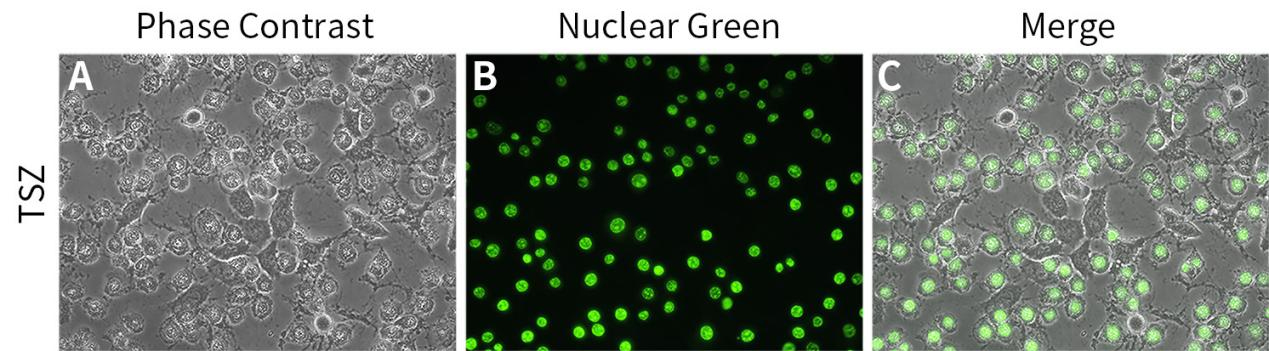

图1. 碧云天死细胞绿色荧光染色试剂盒(Nuclear Green)(C1181)检测坏死细胞的荧光染色效果:
图2.碧云天细胞核绿色荧光染色液(Nuclear Green)(C1186)染色L-929细胞(细胞经固定和通透处理)中细胞核的效果:

图3.碧云天细胞核绿色荧光染色液(Nuclear Green)(C1186)染色大鼠坐骨神经冰冻切片细胞核的效果:

你正在寻找一款坏死细胞用的绿色的细胞核染色试剂盒嘛?
查找了很久,找到的都是DAPI、Hoechst 33342等蓝色荧光染料,又或者是PI、7-AAD等红色荧光染料。
那么今天的试剂盒就非常适合你,碧云天的死细胞绿色荧光染色试剂盒(Nuclear Green)(C1181)、细胞核绿色荧光染色液(Nuclear Green)(C1186)上线啦,本系列产品基于绿色荧光探针Nuclear Green,快速、高效、便捷地对坏死细胞的细胞核进行染色。
产品应用
死细胞绿色荧光染色试剂盒(Nuclear Green)(C1181)提供Assay Buffer,可维持细胞状态,Nuclear Green可用于死细胞染色,从而被用来区分正常细胞与坏死细胞;对于非坏死细胞需要固定、通透并使用RNase A (ST576-ST579)处理后再进行染色;
细胞核绿色荧光染色液(Nuclear Green)(C1186)含有RNase A等核糖核酸酶,能有效消除Nuclear Green对于样品中RNA的染色,使细胞核染色效果更好,可直接加入到经固定、通透处理后细胞或组织切片样品上使用。
产品原理
Nuclear Green,也称SYTOX Green,是一种非细胞膜渗透性的花菁荧光染料,不能穿过具有生物活性的细胞质膜,只能穿过死细胞膜的无序区域而到达细胞核,并嵌入细胞的DNA双螺旋形成Nuclear Green-DNA复合物,荧光强度增加500倍以上,从而产生明亮的绿色荧光,因此Nuclear Green仅能对死细胞染色,从而被用来区分正常细胞与坏死细胞。
发射光谱
Nuclear Green形成DNA复合物的最大激发光波长为504nm,最大发射光波长为528nm。Nuclear Green和DNA复合物的激发光与发射光光谱参考图1。

图1.Nuclear Green和DNA复合物的激发光谱与发射光谱。
检测仪器
荧光显微镜、激光共聚焦显微镜、荧光分光光度计检测或流式细胞仪分析。
产品特点
- 特异性强,荧光明亮:仅染色坏死细胞,与DNA结合后,荧光强度增加500倍以上,绿色荧光明亮;
- 应用广泛:不仅适合于哺乳动物的细胞活性检测,也非常适合于革兰氏阳性菌和革兰氏阴性菌的活性检测;
- 染色时间短:与细胞孵育10-30分钟即可完成染色。
产品效果

图2.碧云天死细胞绿色荧光染色试剂盒(Nuclear Green)(C1181)检测坏死细胞的流式细胞仪检测效果。
注意事项
- Nuclear Green (1000X)为荧光染料,收到时可以根据需要适当进行分装,避免反复冻融,操作时请注意避光;
- 配制Nuclear Green染色工作液时注意避光,且须现配现用,稀释后不能长期保存;
- 对于贴壁细胞,如果希望采用流式细胞仪检测,可以先消化并收集细胞,重悬后参考悬浮细胞的检测方法。
产品信息
| 产品编号 | 产品名称 | 包装 | 产品价格 |
| C1181S | 死细胞绿色荧光染色试剂盒(Nuclear Green) | 1000次 | |
| C1186-100ml | 细胞核绿色荧光染色液(Nuclear Green) | 100ml |
相关产品
| 产品编号 | 产品名称 | 包装 | 产品价格 |
| C0011 | 台盼蓝染色细胞存活率检测试剂盒 | 100次 | |
| C0013 | 中性红细胞增殖及细胞毒性检测试剂盒 | 500次 | |
| C0016 | 乳酸脱氢酶细胞毒性检测试剂盒 | 100次 | |
| C0017 | 乳酸脱氢酶细胞毒性检测试剂盒 | 500次 | |
| C0018S | 乳酸脱氢酶细胞毒性检测试剂盒(WST-8法) | 100次 | |
| C0018M | 乳酸脱氢酶细胞毒性检测试剂盒(WST-8法) | 500次 | |
| C0035 | WST-1细胞增殖及细胞毒性检测试剂盒 | 100次 | |
| C0036 | WST-1细胞增殖及细胞毒性检测试剂盒 | 500次 | |
| C0036L | WST-1细胞增殖及细胞毒性检测试剂盒 | 2500次 | |
| C1053S | 7-AAD细胞活力检测试剂盒 | 200次 | |
| C1053M | 7-AAD细胞活力检测试剂盒 | 1000次 | |
| C1056 | 细胞凋亡与坏死检测试剂盒 | 100次 | |
| C1070S | Annexin V-mCherry/SYTOX Green细胞凋亡检测试剂盒 | 20次 | |
| C1070M | Annexin V-mCherry/SYTOX Green细胞凋亡检测试剂盒 | 50次 | |
| C1075S | YO-PRO-1/PI细胞凋亡与坏死检测试剂盒 | 100次 | |
| C1075M | YO-PRO-1/PI细胞凋亡与坏死检测试剂盒 | 500次 | |
| C2015S | Calcein/PI细胞活性与细胞毒性检测试剂盒 | 100次 | |
| C2015M | Calcein/PI细胞活性与细胞毒性检测试剂盒 | 500次 | |
| C2015L | Calcein/PI细胞活性与细胞毒性检测试剂盒 | 2500次 | |
| C2022-0.2ml | YO-PRO-1 (凋亡与坏死细胞绿色荧光探针) | 1mM×0.2ml | |
| C2022-1ml | YO-PRO-1 (凋亡与坏死细胞绿色荧光探针) | 1mM×1ml | |
| C2025-10ml | YO-PRO-1/RNase细胞核染色液 | 10ml | |
| C2025-50ml | YO-PRO-1/RNase细胞核染色液 | 50ml | |
| C2030S | 细菌死活染色试剂盒(DMAO/PI) | 200次 | |
| C2030M | 细菌死活染色试剂盒(DMAO/PI) | 1000次 |
